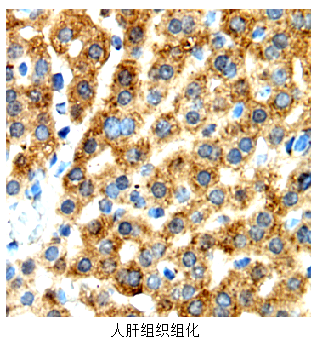
图片

10 年
手机商铺
公司新闻/正文
4166 人阅读发布时间:2024-09-02 09:14
用于流式、免疫组化、免疫荧光的抗体都是通过抗体抗原的识别来进行检测的,但是它们在多个方面存在区别,这些区别主要体现在应用原理、抗体特性、实验流程以及结果呈现等方面。

▲ 抗原抗体特异性结合
以下是对这三种抗体的详细区别的分析:
01 应用原理
流式抗体:主要用于流式细胞术,通过激光激发抗体上的荧光标记物,使其发出荧光信号,流式细胞仪捕获这些信号并进行分析,以实现对细胞表面或细胞内抗原的定量检测。
免疫组化抗体:利用抗原与抗体的特异性结合原理,通过酶标抗体与底物反应显色,对组织切片中的抗原进行定位、定性和定量检测。
免疫荧光抗体:同样基于抗原与抗体的特异性结合,通常是使用荧光标记的二抗来识别结合了一抗的抗原,通过荧光显微镜观察荧光信号,从而对细胞或组织中的抗原进行定位和检测。

▲ 流式抗体用直接法检测抗原,
免疫组化/荧光抗体常用间接法识别抗原
02 抗体特性
流式抗体:通常是针对单一种属的直接带荧光标记的单克隆抗体,具有高度的特异性和灵敏度。
免疫组化抗体:可以是单克隆或多克隆抗体,通常不带荧光标记,通过酶标二抗催化底物显色。
免疫荧光抗体:可以是单克隆或多克隆抗体,通常也不带荧光标记,但可通过荧光标记的二抗进行显色。
03 实验流程
流式抗体:将细胞制成单细胞悬液,加入流式抗体进行孵育,然后使用流式细胞仪进行检测和分析。

免疫组化抗体:需要对组织进行切片、固定、通透等处理,然后加入免疫组化抗体进行孵育,再通过酶标二抗催化底物显色,最后通过显微镜观察结果。

免疫荧光抗体:实验流程与免疫组化类似,但需要使用荧光标记的二抗进行显色,并通过荧光显微镜观察结果。
04 结果呈现
流式抗体:结果通过流式细胞仪分析得到,以图表或数据的形式呈现,如散点图、直方图等,能够直观地展示细胞群体的分布和抗原表达水平。


▲左:FITC-30001流式检测直方图 右:FITC30001流式检测散点图
免疫组化抗体:结果以组织切片的形式呈现,通过显微镜观察切片上的颜色变化(如红色、紫色或蓝色)来判断抗原的定位和表达水平。

▲左:FNab00703 右:FNab08453
免疫荧光抗体:结果同样以组织切片或细胞悬液的形式呈现,但通过观察不同荧光颜色(如绿色、黄色、橙色等)的荧光信号来判断抗原的定位和表达水平。


▲左:FNab02859 右:FNab08858
综上所述,流式抗体、免疫组化抗体和免疫荧光抗体在应用原理、抗体特性、实验流程和结果呈现等方面均存在明显的区别。这些区别使得它们在不同的实验场景中各有优势,共同为生物医学研究提供了强有力的支持。